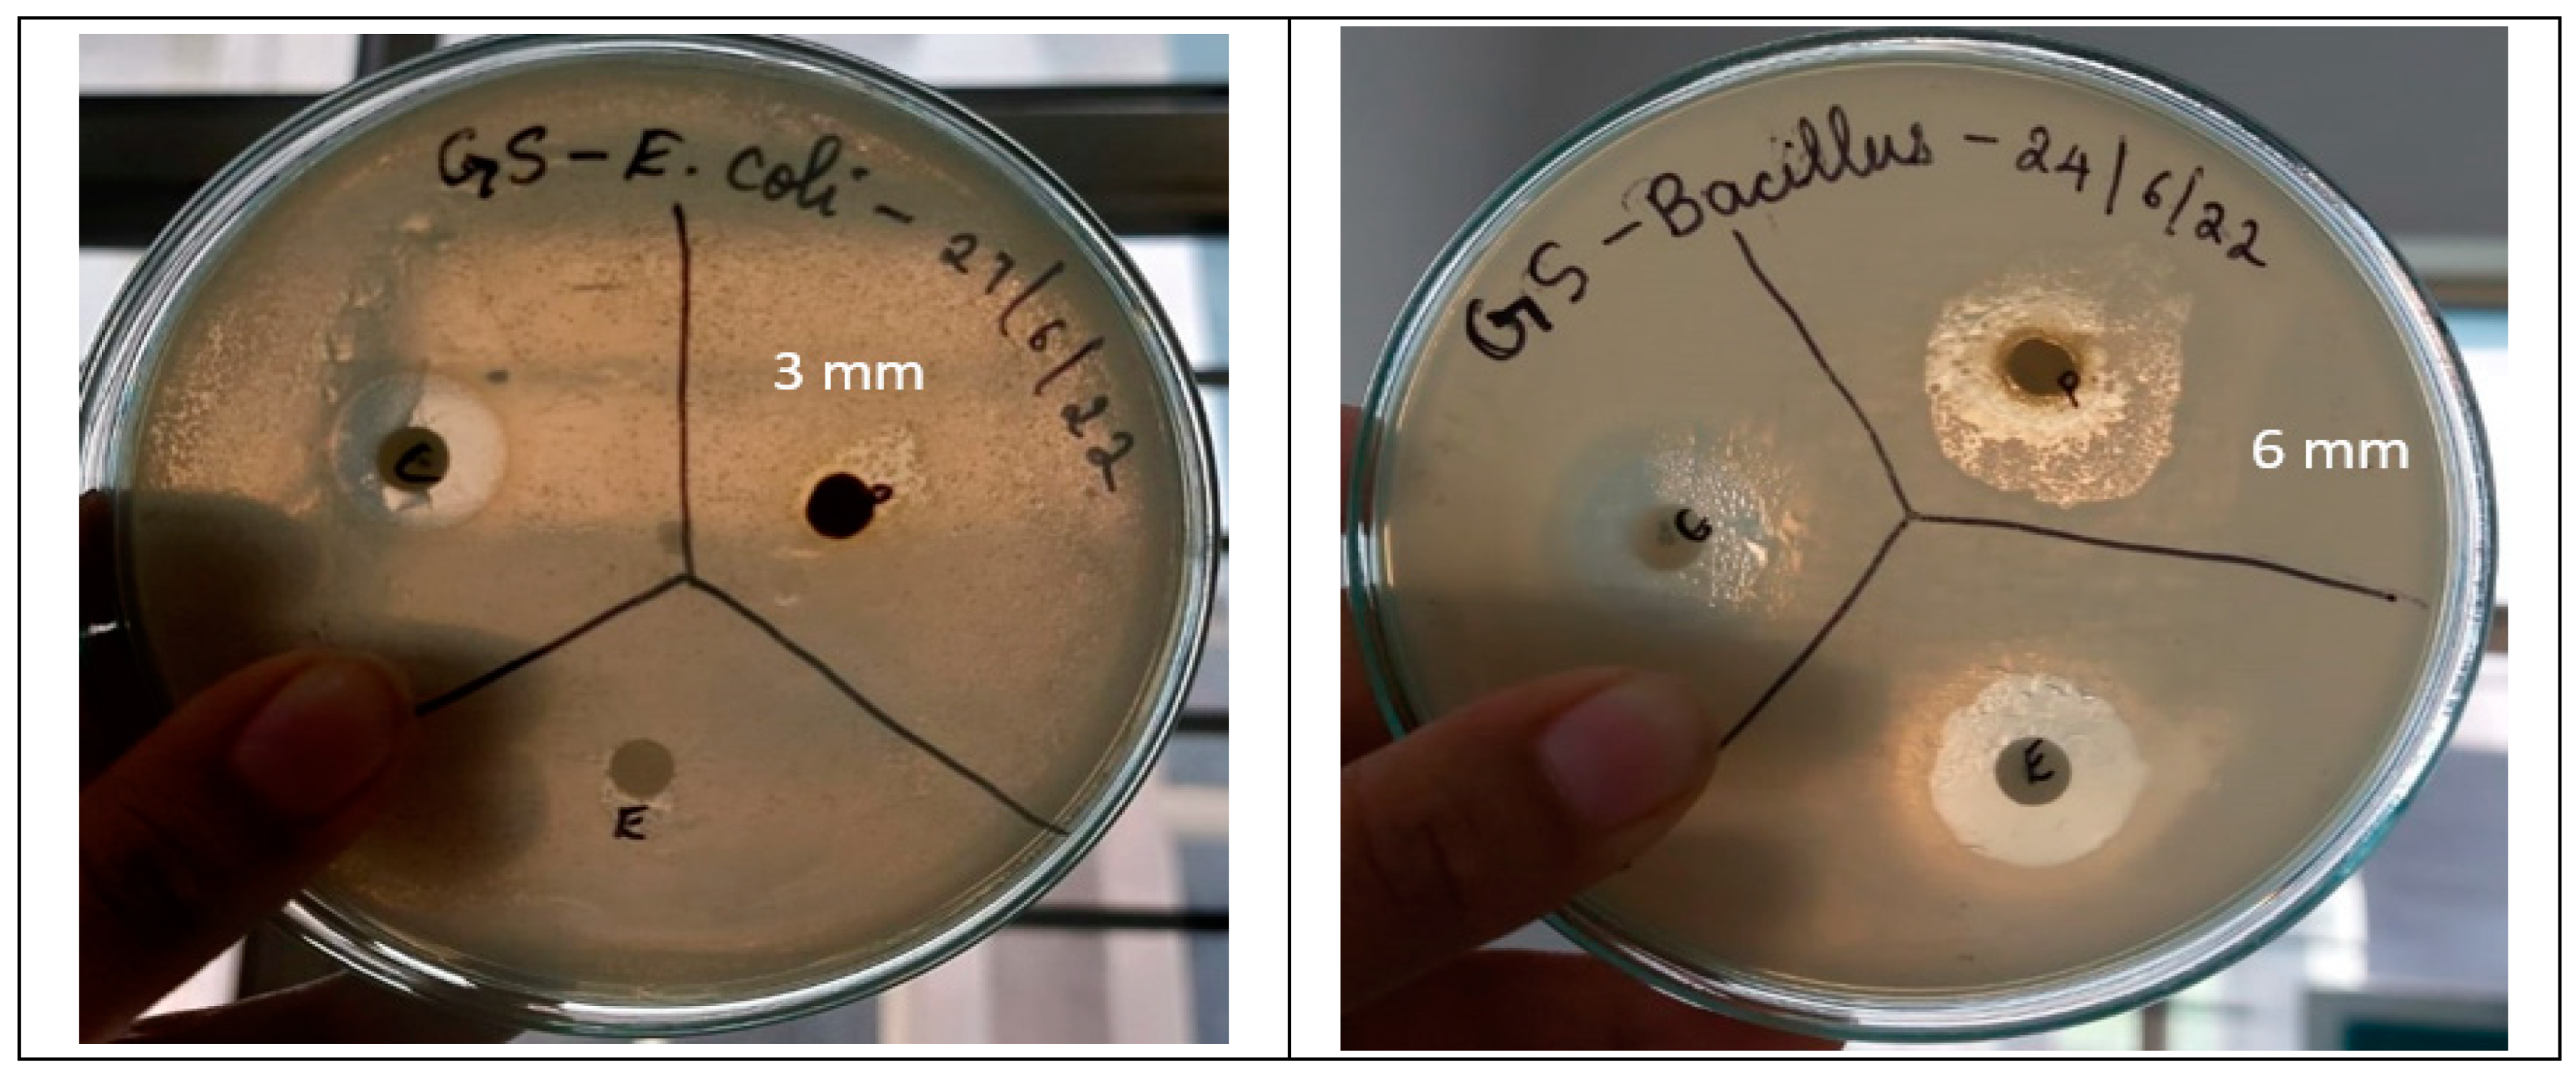
Separations 11 00050 g002

Abstract
The main objective of this research was to perform Gymnema sylvestre (Asclepiadaceae) extract’s phytochemical screening and identify its therapeutic potential. Using a Soxhlet apparatus, the powdered plant material was extracted using ethyl acetate. The preliminary phytochemical analysis confirmed the presence of alkaloids, flavonoids, phenols, glycosides, and steroids. Gas chromatography–mass spectroscopy analysis of the extract was performed and confirmed the presence of 11 compounds. As per the quantitative analysis, the extract exhibited a phenolic content of 948 µg gallic acid equivalent/g dry weight, a total flavonoid content of 398 µg quercetin equivalent/g dry weight, and an alkaloid content of 487 µg atropine equivalent/g dry weight. As per the in vitro cytotoxicity test using A549 cells, the IC50 (half-maximal inhibitory concentration) value for the extract was found to be 76.06 ± 1.26 µg/mL, indicating its cytotoxic effect on the cells. The ethyl acetate extract showed significant antibacterial efficacy, as evidenced by a zone of clearance measuring 3 mm against Escherichia coli and 6 mm against Bacillus subtilis. For anthelmintic activity, the earthworm paralysis time induced by G. sylvestre extract (10 mg/mL) was 28.13 ± 0.8 min, and the time of death was 68.21 ± 1.72 min. In comparison, the reference drug, piperazine citrate (10 mg/mL), caused paralysis in 22.18 ± 1.02 min and resulted in death at 66.22 ± 2.35 min. Similarly, the coagulation time was notably prolonged, with blood clot formation observed at 1 min and 40 s, at a concentration of 1 mg/mL, which underscores the potential anticoagulant or hemostatic modulation properties of G. sylvestre extract. The test extract showed good inhibition of alpha-amylase activity and exhibited an IC50 value of 15.59 µg/mL. The IC50 value for DPPH (2,2-diphenyl-1-picrylhydrazyl)-scavenging activity for the extract was 19.19 µg/mL. Based on the GCMS results, the compound 2,7-dimethyl-undecane was selected for its anticancer potential. Docking studies were conducted with the epidermal growth factor receptor (EGFR) protein, specifically the 5WB7 variant associated with lung cancer. The docking score was −4.5, indicating a potential interaction. Key interaction residues such as ASN328, VAL350, and THR358 were identified. Overall, this research provides valuable insights into the phytochemical composition and diverse biological activities of G. sylvestre extract, offering a foundation for further exploration of its medicinal and pharmacological potential.
1. Introduction
Herbals play a significant role in healthcare, offering alternative and complementary approaches to conventional medicine. Gymnema sylvestre R. Br. ex Schult. (Family Apocynaceae) is commonly referred to as “Gurmar” in Hindi and “madhunashini” in Sanskrit, which translates to “sugar destroyer” or “destroyer of sweet”. This name reflects its traditional use in managing diabetes and reducing sugar cravings. G. sylvestre is also referred to as the “Cowplant” due to its common names, one of which is “Australian cowplant” [1]. These vernacular names are often used in traditional systems of medicine to describe the plant’s properties or appearance. It grows in tropical Asia, including India, Sri Lanka, and Indonesia.
G. sylvestre has a rich historical use in traditional systems of medicine, particularly in Ayurveda. For centuries, it has been valued for its medicinal properties and used for various therapeutic purposes. In Ayurvedic medicine, G. sylvestre has been primarily recognized for its potential benefits in managing diabetes and promoting healthy blood sugar levels.
In traditional practices, the leaves of G. sylvestre were chewed or consumed as an infusion to help reduce the sensation of sweetness and sugar cravings. This usage aligns with the plant’s common name “Gurmar”, which translates to “sugar destroyer” or “destroyer of sweet” [1,2,3,4].
Gymnemic acids, gymnema-saponins, and polypeptide gurmarin are bioactive phytochemicals found in G. sylvestre. These compounds are known for their potential therapeutic effects. G. sylvestre’s capacity to lower sweet cravings and regulate blood glucose and pancreas regeneration make it an intriguing choice for natural diabetes treatment and pharmaceutical research [4]. Gymnemic acids are known for their ability to interact with taste receptors on the tongue, specifically the sweet taste receptors. By binding to these receptors, gymnemic acids can inhibit the sensation of sweetness, thus reducing the craving for sweet foods and potentially assisting in weight management and controlling blood sugar levels [1,2]. Gymnema-saponins have been studied for their potential antidiabetic properties. They may enhance insulin secretion from the pancreas, improve glucose uptake by cells, and help regulate blood sugar levels [3,4]. In addition, polypeptide gurmarin has been shown to have antidiabetic effects by inhibiting the absorption of glucose in the intestine and enhancing insulin production and release from pancreatic beta cells. Gurmarin’s action on glucose metabolism may contribute to its potential therapeutic use in diabetes management [4,5,6,7,8,9]. G. sylvestre has been traditionally utilized for its digestive aid properties, as well as its ability to treat hypercholesterolemia, and it exhibits anti-inflammatory and antibacterial actions [3,4]. These characteristics render it an attractive nutraceutical for pharmacological therapy, with future potential [3].
Previously, G. sylvestre’s water-soluble polysaccharides were studied for their therapeutic effects. Five water-soluble polysaccharides from the plant were tested for immunological and anticancer properties by Wu et al., 2012 [10]. The G. sylvestre polysaccharides showed a significant immunological effect, especially on blood serum hemolysin formation. They also revealed good antitumor effects in a dose-dependent manner against a human myeloid leukemia cell line (U937) and human stomach cancer cells (SGC) [10].
A study conducted by Arunachalam et al. in 2014 demonstrated that the bioactive components of G. sylvestre and its biofunctionalized silver nanoparticles had the ability to inhibit the growth of HT29 human colon adenocarcinoma cells, indicating potential anticancer action [11]. In a study conducted by Arun et al. in 2014, it was found that the aqueous extract of G. sylvestre leaves possesses cytoprotective properties, which contribute to its anti-ulcerogenic, anti-allergic, and antistress effects. The findings support the traditional use of the herb in treating stomach ulcers [12].
The ancient pharmaceutical treatise Shushruta suggests G. sylvestre for glycosuria and urinary problems [12]. Folk medicine, Ayurveda, and homoeopathy have documented G. sylvestre’s therapeutic benefits in the management of diabetes, malaria, snake bites, phlegm, and piles [13].
Over time, G. sylvestre has gained attention beyond traditional medicine, and researchers have started exploring its bioactive compounds and potential therapeutic applications using computational methods. Computational approaches, such as molecular docking and modeling, can help in understanding the interactions between the plant’s phytochemicals and target proteins involved in diabetes management. These methods contribute to a scientific understanding of G. sylvestre’s mechanisms of action and support its potential as a natural remedy for diabetes.
In silico computational approaches are crucial for natural product drug development. They help virtual screen compound libraries, predict target protein structures, optimize lead compounds using molecular docking and QSAR analysis, and predict metabolite profiles and ADMET features. The methods help dereplicate, mine, and integrate different data. Experimental validation is needed to prove natural product-based medication candidates’ efficacy and safety. Combining computational and experimental methods for natural product drug development is effective [14].
In silico computer methods are used to predict and explain a compound’s molecular behavior [14]. Molecular docking is an effective in silico method for predicting these molecules’ locations and assessing the receptor’s ligand-binding affinity [15,16]. To understand stability and interactions, Desmond molecular dynamics simulations are performed on drugs and inhibitor complexes. Therefore, by integrating the historical applications of G. sylvestre and emphasizing the shift towards computational techniques, we highlight the plant’s traditional importance and its historical role in diabetes management, and the current scientific investigation complements and extends this centuries-old wisdom.
Hence, this study thought it worthwhile to further explore G. sylvestre for its therapeutic potential. The study objectives are as follows: (1) Conduct thin-layer chromatography and GCMS analysis to analyze the chemical composition of G. sylvestre ethyl acetate extract. (2) Perform preliminary and quantitative analysis of alkaloids, total phenols, and total flavonoids. (3) Assess the antibacterial activity and determine the minimum inhibitory concentration (MIC). (4) Determine cytotoxic activity against A549 lung cancer cells using the MTT assay. (5) Evaluate the α-amylase inhibitory activity, anticoagulant properties, and anthelminthic activity of G sylvestre extract in vitro.
Furthermore, this study sought to explore the possible effectiveness of G. sylvestre compounds against lung cancer, particularly using A549 cell lines as a model; this approach involved utilizing molecular docking and virtual screening techniques to identify G. sylvestre compounds that have high affinity and the potential to inhibit specific proteins or pathways associated with lung cancer. This research is particularly significant for leveraging the plant’s stem for further study, highlighting its potential as a source of valuable bioactive compounds with therapeutic applications.
2. Methodology
2.1. Sample Collection
G. Sylvestre plant samples were collected in the morning time from a botanical garden in Belagavi district in Karnataka, India, located at latitudes between 15.8° N and 74.8° E on 17 June 2022. The botanical garden is well maintained throughout the year, which is essential for preserving medicinal plants and ensuring their normal chemical constituents are maintained. The plant was identified by an expert botanist and a voucher specimen is preserved in Department of Biotechnology, KLE Technological University, Hubballi, India. The plant was in the flowering stage and free from any disease when it was collected. The stem was washed and dried at room temperature for 6 to 7 days. Further, the dried stem was broken down into small pieces and subjected to the extraction process.
2.2. Extraction
The extraction of the powdered stem sample was carried out in a Soxhlet apparatus. The organic solvent used for the extraction of the plant material was ethyl acetate. The use of ethyl acetate as an organic solvent for extraction in a Soxhlet apparatus provides a good balance of selectivity, solubility, volatility, safety, and environmental considerations. In addition, ethyl acetate has a mild polarity and can dissolve a wide range of phytochemicals. Ethyl acetate’s low boiling point makes it simple to separate from the phytochemicals that have been extracted, which is helpful for condensing extracts and for subsequent processing, making it a suitable choice for extracting compounds from the powdered stem sample [16,17]. A total of 350 mL of ethyl acetate was used for 35 g of powdered plant sample, and the extraction was carried out for 2–3 h at 65 °C. To obtain a concentrated sample, a rotary evaporator was employed, and the resulting concentrated fraction was subsequently stored for further investigation.
2.3. Preliminary and Quantitative Analysis of Phytochemicals
In order to determine the existence of potential bioactive secondary compounds in the ethyl acetate extract of the plant, a preliminary analysis of the plant’s chemical composition was performed, which included measuring the levels of alkaloids, total phenols, and total flavonoids. As mentioned before [18], spectrophotometry was used to measure the concentration of the total phenolic components in the plant extract. Calibration curves were generated for gallic acid (GA) using concentrations ranging from 20 to 100 µg/mL. Ultimately, the phenolic content of the extract was calibrated to gallic acid equivalents (GAEs), and the results were expressed as mg GAE/g dry weight (dw). The calibration curve (y = 0.0028x + 0.0371) was used to compute the overall phenol concentration.
The total flavonoid content was measured by a colorimetric assay employing the aluminum chloride method [19]. Protocols were established to determine quercetin concentrations within the range of 20 to 100 µg/mL. In order to measure the levels of quercetin, a volume of 1 mL from each quercetin concentration was added to a 10 mL volumetric flask that already contained 4 mL of double-distilled water. At time t = 0, three chemicals were introduced: sodium nitrite 5% (0.3 mL), aluminum chloride 10% (0.3 mL), and sodium hydroxide 1M (2 mL). After promptly incorporating 2.4 mL of double-distilled water, the solution was ready for further analysis. The pink color mixture’s absorbance was measured at 510 nm, relative to a blank solution devoid of quercetin. The calibration curve was constructed using the absorbance values of the standard quercetin. The flavonoid concentrations were expressed as mg QE/g dry weight using quercetin equivalents (y = 0.0005x + 0.0054).
Similarly, the quantification of alkaloids was performed as per the bromocresol green (BCG) method. This method is based on the reaction of alkaloids with BCG, forming a yellow-colored product. The content of alkaloids was expressed as mg of atropine equivalents (AE)/g dry weight of plant extract (y = 0.0053x + 0.0309). The details related to calibration curves and equations are provided in Table 1 and Figure 1.
Table 1.
Calibration curves and equations related to quantification of phytochemicals in G. sylvestre extract.
Figure 1.
Standard curves for quantification of alkaloids, flavonoids, and phenols.
2.4. Thin-Layer Chromatography
The plant extracts were subjected to separation through silica thin-layer chromatography as per the standard procedure [20,21]. The solvent employed was a mixture of ethyl acetate and n-hexane in a ratio of 1:5, and the plate was observed using a UV light transilluminator with a wavelength of 312 nm, which is within the UV-A range. The plates were taken out from the TLC tank prior to the solvent front reaching the top of the plate, and the vertical position of the solvent front was indicated using a pencil. The plates were allowed to air-dry in the fume hood. After the plates had dried, the bands were made visible using UV light, and images were taken for the purpose of documentation.
2.5. GC-MS Analysis
As mentioned before [22], a series of solvent extracts of G. sylvestre were subjected to GC-MS analysis. The analysis was performed with a gas chromatography–mass spectrometry (GC-MS) apparatus, namely, the GCMS-QP2010S type, which was fitted with a fused silica column. The separation process was conducted using helium as the carrier gas, which was maintained at a constant flow rate of 1 mL/min. The device received an injection of 1 μL of G. sylvestre ethyl acetate extract through a split injector. The initial temperature of the column was fixed at 80 °C, while the injector temperature was set to 260 °C. During the experimental procedure, the temperature was incrementally raised at a rate of 10 °C per min. The specific parameters employed were as follows: column flow rate of 1.00 mL/min, pressure maintained at 65.0 kPa, linear velocity of 36.8 cm/s, total flow rate of 24.0 mL/min, and a purge flow rate of 3.0 mL/min. The identification of the primary constituents of the plant extract was confirmed through the validation of relative retention time and mass spectra comparisons with the standard compounds.
2.6. Therapeutic Applications
2.6.1. Cytotoxic Activity Using MTT Assay
A549 lung cancer cell lines were used in the study to investigate the cytotoxic effects of plant extract using the MTT assay [23,24]. Accurate analysis of cell growth is possible through the study of the reduction of tetrazolium salts using spectrophotometry. The rate of cell division and the extent to which metabolic activities can lead to cell death are evaluated in this assay [25].
2.6.2. Anthelminthic Activity
Eisenia fetida worms were used for assessing anthelminthic activity. E. fetida worms are readily accessible and serve as a viable model for the evaluation of anthelmintic drugs. The E. fetida worms were obtained from the manure composting area of a chickpea agricultural field. The worms were rinsed with tap water to eliminate any attached dirt. In the experiment, the earthworms were carefully placed in clean and dry Petri dishes. Researchers applied 2 mL of an ethyl acetate plant extract to the earthworms. The worms were closely observed for signs of paralysis, which was defined as the complete absence of any noticeable movement. To confirm paralysis, the researchers even shook the Petri dishes vigorously to ensure that the worms did not respond to external stimulation. The moment at which the worms exhibited no movement despite these efforts was recorded as the time of death [26].
2.6.3. Anticoagulation Assay
Goat blood was employed to assess the anticoagulant properties of plant extracts. The goat blood was collected from a state-run slaughterhouse in Hubballi, Karnataka, India. The goat blood is obtained as a waste byproduct of the normal slaughtering process and the slaughterhouse is known to follow humane conditions for animal slaughter. To separate the blood cells from the plasma, blood samples were subjected to centrifugation at 3000 rpm for a duration of 15 min. Subsequently, a clean and dry test tube was filled with 0.2 mL of plasma, 0.1 mL of ethyl acetate plant extract, and 25 mM CaCl2. The test tube was then positioned in a water bath and heated to a temperature of 37 °C. For the control group, an equivalent volume of 0.9% saline solution was substituted for the plant extract solution. To measure the clotting time, which served as the prothrombin time (PT), the test tubes were gently tilted every 5 s, and a stopwatch was used to record the duration it took for the blood to clot [27]. The assay was performed using the PT in vitro liquid reagent assay kit (Atlas Medical, Blankenfelde-Mahlow, Germany). The experiment was performed three times and the mean and standard deviation was calculated.
2.6.4. Antibacterial Activity
Extract of G. sylvestre was tested against Escherichia coli and Bacillus subtilis using the disc diffusion method to determine their antimicrobial efficacy [28]. The plant extract was tested at a concentration of 10 µg/mL.
2.6.5. Minimum Inhibitory Concentration (MIC) Determination
The agar dilution method was used to determine the minimum inhibitory concentration of the ethyl acetate extract. As previously stated, stock solutions were made and the minimal inhibitory concentration was evaluated utilizing a range of concentrations, i.e., from 10 to 500 µg/mL, against test organisms [29,30]. The MICs were compared to the standard antibiotic ciprofloxacin.
2.6.6. In Vitro α-Amylase Inhibitory Studies
The α-amylase inhibition assay was performed using the 3,5-dinitrosalicylic acid (DNSA) method [31]. The extract of G. sylvestre was diluted in a small amount of 10% DMSO and then dissolved in a buffer solution (Na2HPO4/NaH2PO4 at a concentration of 0.02 M, NaCl at a concentration of 0.006 M) at pH 6.9. This resulted in concentrations of the extract ranging from 10 to 300 μg/mL. Alpha-amylase solution with a concentration of 2 units/mL was combined with an extract in a volume of 200 μL. The mixture was then incubated at a temperature of 30 °C for a duration of 10 min. Subsequently, 200 μL of a 1% starch solution in water (w/v) was added to each tube and allowed to incubate for 3 min. The reaction was stopped by adding 200 μL of DNSA reagent, which consisted of 12 g of sodium potassium tartrate tetrahydrate dissolved in 8 mL of 2 M NaOH and 20 mL of 96 mM 3,5-dinitrosalicylic acid solution. The mixture was then heated in a water bath at 85–90 °C for 10 min. The solution was cooled to room temperature and then diluted with 5 mL of distilled water. The absorbance of the solution was subsequently measured at a wavelength of 540 nm using a UV–Visible spectrophotometer. A blank sample was created by substituting the plant extract with 200 μL of buffer, resulting in a solution with 100% enzyme activity. A control reaction was also produced using the plant extract at each concentration without the enzyme solution. A positive control sample was created by employing Acarbose at concentrations ranging from 100 μg/mL to 2 μg/mL. The reaction was carried out in a manner similar to the experiment using the plant extract, as described before.
The α-amylase inhibitory activity was quantified as a percentage of inhibition and was computed using the provided equation. The percentage of α-amylase inhibition was graphed versus the log concentration of the extract, and the IC50 values were derived from the graph.
The formula represents the calculation of percentage inhibition for α-amylase activity. It is calculated by subtracting the absorbance value of the test sample (A Test) from the absorbance value of the control sample (A control). This difference is then divided by the absorbance value of the control sample. The resulting value is multiplied by 100 to express the inhibition as a percentage.
2.6.7. DPPH Activity
The radical-scavenging activity of the plant extract was evaluated using the methodologies outlined by Rice-Evans et al. (1997) [32]. A mixture was prepared by combining 100 μL of a sample solution in ethanol with varying concentrations (w/v) and 100 µL of a DPPH radical solution in ethanol with a concentration of 60 M. The solution was subjected to incubation for a duration of 30 min at ambient temperature under conditions of low light. Subsequently, the absorbance at a wavelength of 517 nm was quantified using a UV–VIS spectrophotometer. The reference standard employed in this study was ascorbic acid. The DPPH-scavenging activity of each sample was calculated using the provided equation.
The variable “At” represents the absorbance of the test sample, whereas “Ac” represents the absorbance of the control reaction, which consists of a mixture of 100 µL of ethanol and 100 µL of DPPH solution. The experiment was conducted on three separate occasions. The IC50 value was found for each of the utilized samples. The reaction mixture’s lower absorbance was reflective of greater levels of free radical activity.
2.7. Docking of Molecules
The potential mechanism of anti-proliferative action was elucidated through molecular docking studies of the active components of the extract. These studies were carried out with the goal of elucidating this mechanism. Consequently, molecular docking was carried out to investigate the possible interactions involving the epidermal growth factor receptor (EGFR). The protein data bank was consulted to acquire the three-dimensional crystal structure of the molecules (PDB ID: 5wb7) [33].
The choice of EGFR as the target for molecular docking studies was motivated by its significance in cellular proliferation and its involvement in various diseases, including cancer. EGFR is a receptor protein that plays a crucial role in cell growth and division. By investigating the interactions involving EGFR, we can gain insights into the potential anti-proliferative mechanism of the active components of the extract. In the case of the chosen molecule, 2,7-dimethylundecane, its selection for further study was based on GCMS analysis data. The three-dimensional structures of 2,7-dimethylundecane, which have the PubChem identifier 519383, have been extracted from that database. In preparation for docking, proteins were produced with the help of Biovia Discovery Studio 2021 Client. After that, the docking procedure was carried out by utilizing Autodock 4.2.6 software, which was based on the Lamarckian genetic algorithm (LGA). The LGA was run for 10 runs, and the starting population size of both the enzymes and the DNA was set at 150 individuals. Using Biovia Discovery Studio 2020 Client, the docking analysis and 3D visualizations were carried out. Simulation studies were performed in Schrodinger software version 2021-2.
3. Results
3.1. Qualitative and Quantitative Phytochemical Analysis of G. sylvestre Extract
The preliminary analysis results indicated the existence of alkaloids, glycosides, flavonoids, tannins, steroids, anthraquinones, resins, and saponins in the tested extract (Table 2) [34,35,36,37,38,39,40,41,42,43]. Based on the quantitative results, the extract was determined to have a phenolic content of 948 µg GAE/g of dry weight, and a total flavonoid content of 398 µg QE/g of dry weight. The concentration of alkaloids was determined to be 487 µg AE/g of dry weight.
Table 2.
Initial phytochemical test outcomes G. sylvestre extract.
3.2. Antibacterial Activity
The antibacterial activity of G. sylvestre was tested against Gram-negative Escherichia coli and Gram-positive Bacillus subtilis. The ethyl acetate extract demonstrated significant antibacterial efficacy, as evidenced by a zone of inhibition (ZOI) measuring 3 mm against Escherichia coli and 6 mm against Bacillus subtilis. Whereas, the standard drug Ciprofloxacin showed a 6 mm ZOI for both bacteria (Table 3 and Figure 2).
Table 3.
Antibacterial activity result of G. sylvestre extract against Escherichia coli and Bacillus subtilis.
Figure 2.
Zone of inhibition induced by G. sylvestre extract. C = ciprofloxacin; P = plant extract; E = ethyl acetate (control).
3.3. Minimum Inhibitory Concentration (MIC)
The minimum inhibition concentration of the plant extract was analyzed against Bacillus subtilis and Escherichia coli by taking different concentrations of the extract. Their MIC values were organism-specific. The ethyl acetate extract exhibited significantly low MIC values of 300 and 500 µg/mL for Escherichia coli and Bacillus subtilis, respectively. The standard antibiotic ciprofloxacin showed a value of 0.013 and 0.125 µg/mL for Escherichia coli and Bacillus subtilis, respectively (Table 3).
3.4. In Vitro α-Amylase Inhibitory Studies
Alpha-amylase inhibition activity was analyzed to determine the antidiabetic potential of G. sylvestre. By assessing the relationship between extract concentrations and the percentage of α-amylase inhibition, the IC50 values were determined. The G. sylvestre extract exhibited an IC50 value of 15.59 µg/mL, which was comparable to that of the standard drug Acarbose, which showed an IC50 value of 9.98 µg/mL (Figure 3).
Figure 3.
IC50 (μg/mL) values of α-amylase inhibitory activity of (A) ethyl acetate extract of G. sylvestre; (B) Acarbose standard drug. The concentration (mg/mL) was converted to log (concentration) for the determination of IC50 using non-linear regression (curve fit) in GraphPad Prism-V5.
3.5. Antioxidant Activity
The antioxidant activity of the plant extract was evaluated by comparing it with ascorbic acid, which served as the standard antioxidant (Table 4). The findings indicated that the plant extract demonstrated significant antioxidant activity, as evidenced by 68.47 ± 0.132 inhibition at a concentration of 50 µg/mL. This was comparable to that of the standard ascorbic acid (88.16 ± 0.2). The IC50 values for DPPH-scavenging activity for the extract and ascorbic acid were found to be 19.19 and 7.59 µg/mL, respectively (Figure 4).
Table 4.
DPPH assay results of G. sylvestre plant extract.
Figure 4.
DPPH assay IC50 calculated by the graph. The concentration (mg/mL) was converted to log (concentration) for the determination of IC50 using non-linear regression (curve fit) in GraphPad Prism-V5.
3.6. Thin-Layer Chromatography
The crude extract was separated by thin-layer chromatography into separate bands for analysis, as shown in Figure 4. The TLC fingerprinting of the extract revealed nine prominent spots with their respective retention factors (Rf), indicative of the presence of active phytochemicals in the extract (Figure 5). Overall, the TLC fingerprinting results suggest that the crude extract contains multiple active phytochemicals.
Figure 5.
TLC Photo-documentation of G. sylvestre extract depicting the separated bands with nine distinct spots. The visible distinct spots are numbered 1–9.
3.7. GC-MS Analysis
GC-MS analysis showed the presence of 11 different chemical compounds in the plant extract (Figure 6 and Table 5). From the chromatogram, eleven compounds with a retention time ranging from 13.05 to 47.04 were observed.
Figure 6.
GC-MS chromatogram of G. sylvestre extract.
Table 5.
Results of GC-MS analysis of G. sylvestre extract.
3.8. Docking and Simulation Studies
After decoding the GCMS analysis results and the literature survey, this review assumed that Undecane,2,7-dimethyl- could be screened further as a potential candidate for anticancer activity. In this research, compounds were selected for further investigation, along with the EGFR protein variant known as 5WB7, which is associated with lung cancer. Detailed structural and informational data about these molecules are provided in Figure 7. Molecular docking studies were conducted to assess their interaction, and the findings revealed a docking score of −4.5. Furthermore, this study identified specific amino acid residues involved in the interaction, namely, ASN328, VAL350, and THR358 (Table 6 and Figure 7) [44,45].
Figure 7.
(A) 3D Image of protein–ligand complex of 2,7-Dimethyl-Undecane and 5WB7 protein; (B) ligand information; (C) docking interaction between protein and ligand; (D) interaction sites of protein–ligand complex.
Table 6.
Docking result of protein and ligand with interaction sites.
The docking analysis of the protein–ligand interaction between 2,7-Dimethylundecane and the protein of interest revealed a docking score of −4.5 kcal/mol. This indicates a strong binding affinity between the ligand and the protein. The interaction residues involved in hydrophobic interactions were ASN328, VAL350, and THR358. These findings suggest that 2,7-Dimethylundecane occupies a hydrophobic binding pocket within the protein, which could potentially impact its biological activity.
3.8.1. Protein–Ligand Root Mean Square Deviation (RMSD)
The protein’s RMSD development is depicted in Figure 8 (left Y-axis). The RMSD was determined by aligning all protein frames onto the reference frame backbone and then selecting a subset of atoms to compare. Analyzing the RMSD determined if the simulation had stabilized or not, as the simulations were centered on a mean temperature. Modifications on the scale of 1–3 worked quite fine, which was appropriate for low-molecular-weight globular proteins. However, shifts of a significantly bigger magnitude suggested that the protein had undergone a major conformational shift while being simulated. The accuracy of the simulation was also crucial, as it reached a steady state when the RMSD values stopped fluctuating.
Figure 8.
Protein–ligand RMSD (root mean square deviation) plot.
The ligand’s relative stability to the protein and its binding pocket is shown by the ligand RMSD (right Y-axis). The ‘Lig fit Prot’ graphic (Figure 8) displays the RMSD of the ligand when the protein–ligand complex was first aligned on the reference protein backbone and the RMSD of the ligand heavy atoms was assessed.
3.8.2. Root Mean Square Fluctuation (RMSF) Simulation
RMSF is typically used to assess the flexibility or dynamic behavior of individual atoms or groups of atoms within a molecule or a complex; it is useful for characterizing local changes along the protein chain. In this study, the RMSF simulation revealed that the ligand is flexible and can adopt various conformations within the binding site of the protein (Figure 9 and Figure 10).
Figure 9.
Protein RMSF (root mean square fluctuation) plot depicting protein fluctuations during the simulation.
Figure 10.
Ligand RMSF plot depicting ligand fluctuations during the simulation.
3.8.3. The Protein–Ligand Contact Plot
Throughout the simulation, protein–ligand interactions were observable. As illustrated in Figure 11, these interactions were categorized into four types of ‘contacts’ between proteins and their ligands: hydrogen bonds, hydrophobic interactions, ionic interactions, and water bridge interactions.
Figure 11.
Protein–ligand contact plot depicting protein interactions with the ligand throughout the simulation.
3.8.4. The Ligand Torsions Plot
The ligand torsions plot summarizes the conformational evolution of every rotatable bond (RB) in the ligand throughout the simulation trajectory (0.00 through 150.15 ns). Looking at the histogram and torsion potential relationships gives insights into the conformational strain the ligand underwent to maintain a protein-bound conformation (Figure 12).
Figure 12.
The ligand torsions plots summarize the data on the dial plots by showing the probability density of the torsion.
3.9. Cytotoxic Activity
The lung cancer (A549) cell line was used in an in vitro assay to determine the cytotoxic potential of the G. sylvestre stem extract. Cell viability was evaluated by using the MTT assay with different concentrations (100, 50, 25, 12.5, 6.26, and 3.125 µg/mL) of G. sylvestre stem extract. The positive control, doxorubicin, was tested in triplicate using serial dilution [46] (Figure 13). A negative correlation was detected between the concentration of the extract and the cell viability. The IC50 value was found to be 76.06 ± 1.24 µg/mL. The IC50 value of standard Doxorubicin against the A549 cell line was found to be 9.1 ± 0.8 µg/mL.
Figure 13.
Cytotoxic activity of G. sylvestre against A549 cell line.
3.10. Anthelminthic Activity
The crude extract’s phytochemical study confirmed the presence of tannins and other chemical components. Tannins have been shown to have anthelmintic effects [47,48,49,50]. The time of paralysis and death of earthworms for G. sylvestre extract was found to be 28.13 ± 0.8 min and 68.21 ± 1.72 min, respectively, at a concentration of 10 mg/mL. The reference drug piperazine citrate (10 mg/mL) showed the time of paralysis and time of death as 22. 18 ± 1.02 min and 66.22 ± 2.35 min, respectively (Figure 14). The extract’s wormicidal efficacy towards earthworms raises the possibility that it could be beneficial against human parasitic infections as well [51].
Figure 14.
Anthelminthic activity of G. sylvestre against Eisenia foetida.
3.11. Anticoagulation Activity
The anticoagulant activity of the extract revealed significant anticoagulant properties. In the current study, the time taken for the formation of a blood clot (Figure 15) after adding G. sylvestre extract to the plasma was 1 min 40 s ± 11 s, at a concentration of 1 mg/mL.
Figure 15.
Anticoagulation activity of G. sylvestre extract.
4. Discussion
Natural products play a pivotal role in healthcare by providing a rich source of therapeutic compounds derived from plants, fungi, marine organisms, and other biological sources. These compounds, often referred to as secondary metabolites, have been instrumental in the development of numerous pharmaceuticals and therapies. Natural products offer a diverse array of bioactive molecules with the potential to treat a wide range of diseases, from pain management to the treatment of cancer and infectious diseases [52]. Additionally, they often have a lower risk of adverse effects compared to synthetic drugs. Harnessing the power of natural products not only provides effective treatment options but also highlights the importance of biodiversity conservation and the sustainable utilization of natural resources, making them integral to modern healthcare and drug discovery efforts.
This investigation aimed to evaluate the phytochemical composition of G. sylvestre and ascertain its medicinal properties. Standardized procedures were employed to assess the presence of various phytochemicals, and the concentration of alkaloids, flavonoids and phenolics was quantified, which revealed their presence in significant quantity. In addition, the TLC fingerprinting of the extract revealed nine prominent spots indicative of the presence of a diverse array of active phytochemicals in the extract. Phenolic compounds and flavonoids are widely recognized for their antioxidant properties and significant bioactive characteristics, which have garnered considerable attention for their potential contributions to human health, disease treatment, and prevention [53]. This diversity enhances the prospects of G. sylvestre as a valuable resource for the development of novel biomedical interventions and therapeutic agents, underscoring its importance in the field of medical research and healthcare.
The antibacterial activity against Escherichia coli and Bacillus subtilis was assessed using the disc diffusion method, revealing a zone of inhibition of 3 mm and 6 mm, respectively. The MIC for Escherichia coli and Bacillus subtilis was 350 and 500 µg/mL, respectively. The determination of MIC holds significant importance across diverse applications, encompassing the development of natural antimicrobial agents, the evaluation of plant extract potential for medicinal or preservative purposes, and the formulation of herbal remedies. This critical parameter assists researchers and practitioners in identifying the most efficacious plant extracts for combating specific microbial pathogens, thus optimizing the utilization of these valuable botanical resources [54].
The present investigation involved the evaluation of the in vitro alpha-amylase inhibitory activity of G. sylvestre extract, which demonstrated a significant inhibition of the enzyme. Postprandial hyperglycemia, characterized by elevated blood glucose levels following meal consumption, represents a critical concern in the management of diabetes mellitus. This condition can be effectively controlled through the inhibition of alpha-amylase activity, an enzyme responsible for converting starch into glucose, thereby modulating glucose absorption into the bloodstream. The inhibition of alpha-amylase activity results in delayed or reduced starch digestion and absorption, consequently lowering postprandial blood sugar levels and potentially reducing the requirement for exogenous insulin administration. A comprehensive understanding of these inhibitors and their mechanisms of action is essential for advancing the development of novel antidiabetic therapies aimed at mitigating postprandial hyperglycemia and improving the overall quality of life for individuals with diabetes [55].
Furthermore, antioxidant activity was evaluated using the DPPH radical-scavenging assay. The results revealed that the plant extract exhibited remarkable antioxidant activity. This antioxidant potential can be attributed to the presence of bioactive phytochemicals present in the extract. Natural antioxidants therefore have the capacity to counteract uncontrolled oxidative stress and restore cellular equilibrium. Therefore, different oxidative stress-induced diseases can be managed by natural antioxidants [56]. These findings corroborate the earlier research, which reported the significant antioxidant activity of G. sylvestre [57,58].
Lung cancer is one of the most prevalent and deadliest forms of cancer worldwide. The A549 cell line, derived from a human lung carcinoma, provides a representative model of lung cancer cells. The cytotoxic effects of plant extracts on the A549 cell line were tested using the MTT assay, which revealed an IC50 value 76.06 ± 1.24. The results of the cytotoxicity study using the MTT assay on the A549 cell line have provided valuable insights into the potential therapeutic properties of the tested plant extracts. The IC50 value suggests a moderate level of cytotoxicity, signifying that the plant extracts have the potential to inhibit growth or induce cell death in these lung cancer cells [59].
Molecular docking is a computational simulation technique used to predict the binding affinity and binding mode of a small molecule (ligand) to a protein (receptor). It helps researchers understand how a drug or compound interacts with a specific protein target. The compound in question, Undecane,2,7-dimethyl, was tested for its in silico docking characteristics. In the context of this study, it is the ligand that is docked to the EGFR protein, which is the target protein, specifically the 5WB7 variant. EGFR is a receptor protein that plays a crucial role in cancer growth and is often targeted in cancer therapy. In this study, the 5WB7 variant of EGFR is used, which likely has specific characteristics relevant to lung cancer. The docking score of −4.5 is a numerical value that represents the predicted binding affinity between the compound (Undecane,2,7-dimethyl-) and the EGFR protein. A lower docking score generally indicates a stronger binding interaction. In this case, −4.5, suggests a relatively strong binding between the compound and EGFR. The interaction residues, ASN328, VAL350, and THR358, indicate specific amino acid residues on the EGFR protein that are involved in binding with the compound. These residues likely form hydrogen bonds, hydrophobic interactions, or other types of interactions with the ligand, stabilizing the binding complex. The current molecular docking study suggests that Undecane,2,7-dimethyl- has a strong binding affinity for the EGFR protein (5WB7 variant) from lung cancer. The docking score of −4.5 and the identified interaction residues (ASN328, VAL350, THR358) indicate that the compound forms stable interactions with the protein, which is a promising finding in the context of anticancer drug development. Further experimental studies and validations may be needed to confirm the efficacy of this compound as a potential anticancer agent [60].
Anthelmintics are drugs that are used to battle parasitic worms. They can function locally within the stomach to eradicate intestinal worms or systemically to target adult helminths throughout the body. The use of natural anthelmintic is critical for treating parasitic infections. Researchers are employing mature earthworms known as Eisenia foetida to investigate the efficiency of natural anthelmintic [61]. These earthworms resemble human intestinal roundworm parasites in morphological and physiological characteristics. The earthworm’s mucilaginous outer layer is made up of intricate polysaccharides. The earthworm can move easily since this layer is slimy. Any degradation of the mucopolysaccharide barrier exposes the outer layer, restricting motion and perhaps leading to paralysis. Alkaloids may affect the earthworm’s central nervous system and cause paralysis. In the current study, the G. sylvestre extract demonstrated significant wormicidal activity against earthworms, with a time of paralysis and time of death of 28.13 ± 0.8 min and 68.21 ± 1.72 min, respectively, which was similar to the standard drug piperazine citrate. In light of these findings, it appears that the extract may have a potential use in the fight against human parasite illnesses.
Many bioactive compounds commonly found in fruits and vegetables have been shown to influence coagulation processes. The prothrombin time assessment of the G. sylvestre extract revealed a clot formation time of 1 min and 40 s. This observation suggests potential anticoagulant activity associated with the phytochemicals present in the plant extract. Accumulating research suggests that employing bioactive phytochemicals may contribute to a reduced risk of atherosclerosis and heart disease [62]. As a result, there is a growing interest in exploring the anticoagulant properties of medicinal herbs as potential therapeutic options [60]. Moreover, previous research has investigated the anticoagulant effects of various plant extracts from Artemisia dracunculus [63]. These findings collectively underscore the potential cardiovascular health benefits associated with the regular consumption of these plant extracts [64].
5. Conclusions
In conclusion, the investigation of G. sylvestre extract has revealed its rich phytochemical composition, including flavonoids and phenolics, as well as its diverse bioactivities. This extract exhibits promising antimicrobial, alpha-amylase-inhibitory, antioxidant, anthelmintic, anticoagulant, and cytotoxic properties. Further molecular docking results indicate a strong binding affinity with EGFR, supporting its potential as an anticancer agent. These findings underscore its significant potential in pharmaceutical and biomedical applications, from antimicrobial agents to diabetes management and cancer therapy. Moreover, its utility in combating parasitic infections and potential cardiovascular benefits make it a valuable resource for modern healthcare and drug discovery efforts.
Limitations
While this study on the exploration of bioactive phytochemicals in G. Sylvestre and their therapeutic potential provides valuable insights, it is important to acknowledge certain limitations: (1) In vitro evaluation of cytotoxicity, antibacterial efficacy, anthelmintic activity, coagulation time, and antidiabetic and antioxidant activities was conducted. While these experiments provide valuable initial insights, it is essential to validate these findings using in vivo models, and eventually clinical studies, to ascertain the true therapeutic potential of the G. sylvestre extract. (2) The mechanistic pathways responsible for the mechanism of biological activity would be necessary to gain a deeper understanding of the mode of action of the bioactive compounds present in the extract. (3) The computational docking study performed to evaluate the interaction between the selected compound and the EGFR protein is exploratory in nature. While it provides initial insights, it should be noted that computational predictions are not a substitute for experimental validation. Further experimental studies, such as binding assays or structural biology techniques, would be required to confirm and characterize the interaction. Sample specificity: This study focused on a specific plant species, Gymnema sylvestre, and utilized ethyl acetate as the extraction solvent. It is important to acknowledge that different plant species and extraction solvents may yield varying phytochemical profiles and biological activities. Therefore, the findings of this study may not be directly generalizable to other plant extracts or extraction methods. By recognizing these limitations, we aim to provide a transparent assessment of the scope and potential implications of this study, while also highlighting areas for further research and validation.
Author Contributions
Conceptualization, U.M.M., S.M. and D.Y.; Formal analysis, I.A.S., A.A.K. and B.A.M.; Funding acquisition, Y.S.A.; Investigation, U.M.M., S.M., D.Y. and S.S.M.; Methodology, U.M.M., S.M., Y.S.A., A.A.K. and S.S.M.; Resources, Y.S.A., I.A.S. and D.Y.; Software, U.M.M. and B.A.M.; Writing—original draft, S.M. and I.A.S.; Writing—review and editing, Y.S.A., A.A.K., B.A.M. and S.S.M. All authors have read and agreed to the published version of the manuscript.
Funding
The authors are thankful to the Deanship of Scientific Research at Najran University for funding this work under the Research Group Funding program grant code (NU/RG/MRC/12/4).
Data Availability Statement
The original contributions presented in the study are included in the article, further inquiries can be directed to the corresponding authors.
Acknowledgments
The authors are thankful to the Deanship of Scientific Research at Najran University for funding this work under the Research Group Funding program grant code (NU/RG/MRC/12/4). The authors would like to express sincere gratitude to AlMaarefa University, Riyadh, Saudi Arabia for supporting this research; and KLE technological University, Hubballi-580031, India, for supporting this work.
Conflicts of Interest
The authors declare no conflicts of interest.
References
- Kanetkar, P.; Singhal, R.; Kamat, M. Gymnema sylvestre: A Memoir. J. Clin. Biochem. Nutr. 2007, 41, 77–81. [Google Scholar] [CrossRef]
- Dateo, G.P., Jr.; Long, L., Jr. Gymnemic Acid, the Antisaccharine Principle of Gymnema sylvestre. Isolation and Heterogeneity of Gymnemic Acid A1. J. Agric. Food Chem. 1973, 21, 899–903. [Google Scholar] [CrossRef]
- Khan, F.; Sarker, M.M.R.; Ming, L.C.; Mohamed, I.N.; Zhao, C.; Sheikh, B.Y.; Tsong, H.F.; Rashid, M.A. Comprehensive Review on Phytochemicals, Pharmacological and Clinical Potentials of Gymnema sylvestre. Front. Pharmacol. 2019, 10, 1223. [Google Scholar] [CrossRef]
- Tiwari, P.; Mishra, B.N.; Sangwan, N.S. Phytochemical and Pharmacological Properties of Gymnema sylvestre: An Important Medicinal Plant. BioMed Res. Int. 2014, 2014, 830285. [Google Scholar] [CrossRef]
- Kurihara, Y. Antisweet Activity of Gymnemic Acid A1 and Its Derivatives. Life Sci. 1969, 8, 537–543. [Google Scholar] [CrossRef]
- Gent, J.F.; Hettinger, T.P.; Frank, M.E.; Marks, L.E. Taste Confusions Following Gymnemic Acid Rinse. Chem. Senses 1999, 24, 393–403. [Google Scholar] [CrossRef] [PubMed]
- Sanematsu, K.; Kusakabe, Y.; Shigemura, N.; Hirokawa, T.; Nakamura, S.; Imoto, T.; Ninomiya, Y. Molecular Mechanisms for Sweet-Suppressing Effect of Gymnemic Acids. J. Biol. Chem. 2014, 289, 25711–25720. [Google Scholar] [CrossRef] [PubMed]
- Gardner, Z.; McGuffin, M. American Herbal Products Association’s Botanical Safety Handbook, 2nd ed.; CRC Press: Boca Raton, FL, USA, 2013; ISBN 978-1466516946. [Google Scholar]
- Brala, P.M.; Hagen, R.L. Effects of Sweetness Perception and Caloric Value of a Preload on Short Term Intake. Physiol. Behav. 1983, 30, 1–9. [Google Scholar] [CrossRef]
- Wu, X.; Mao, G.; Fan, Q.; Zhao, T.; Zhao, J.; Li, F.; Yang, L. Isolation, Purification, Immunological and Anti-tumour Activities of Polysaccharides from Gymnema sylvestre. Food Res. Int. 2012, 48, 935–939. [Google Scholar] [CrossRef]
- Arunachalam, K.; Arun, L.B.; Annamalai, S.K.; Arunachalam, A.M. Potential anticancer properties of bioactive compounds of Gymnema sylvestre and its biofunctionalized silver nanoparticles. Int. J. Nanomed. 2015, 10, 31–41. [Google Scholar] [CrossRef] [PubMed]
- Arun, L.B.; Arunachalam, A.M.; Arunachalam, K.D.; Kumar, K.A. In vivo anti-ulcer, anti-stress, anti-allergic, and functional properties of Gymnemic Acid Isolated from Gymnema sylvestre R Br. BMC Complement. Altern. Med. 2014, 14, 70. [Google Scholar] [CrossRef]
- Pothuraju, R.; Sharma, R.K.; Chagalamarri, J.; Jangra, S.; Kumar Kavadi, P. A Systematic Review of Gymnema Sylvestre in Obesity and Diabetes Management. J. Sci. Food Agric. 2014, 94, 834–840. [Google Scholar] [CrossRef] [PubMed]
- Dege, N.; Gökce, H.; Doğan, O.E.; Alpaslan, G.; Ağar, T.; Muthu, S.; Sert, Y. Quantum Computational, Spectroscopic Investigations on N-(2-((2-Chloro-4, 5-Dicyanophenyl)Amino)Ethyl)-4-Methylbenzenesulfonamide by DFT/TD-DFT with Different Solvents, Molecular Docking and Drug-Likeness Researches. Colloids Surf. A Physicochem. Eng. Asp. 2022, 638, 128311. [Google Scholar] [CrossRef]
- Trott, O.; Olson, A.J. AutoDock Vina: Improving the Speed and Accuracy of Docking with a New Scoring Function, Efficient Optimization, and Multithreading. J. Comput. Chem. 2010, 31, 455–461. [Google Scholar] [CrossRef]
- Mert Ozupek, N.; Cavas, L. Triterpene Glycosides Associated Antifouling Activity from Holothuria tubulosa and H. polii. Reg. Stud. Mar. Sci. 2017, 13, 32–41. [Google Scholar] [CrossRef]
- Adefuye, A.O.; Ndip, R.N. Phytochemical Analysis and Antibacterial Evaluation of the Ethyl Acetate Extract of the Stem Bark of Bridelia micrantha. Pharmacogn. Mag. 2013, 9, 45–50. [Google Scholar] [CrossRef]
- Singleton, V.L.; Orthofer, R.; Lamuela-Raventós, R.M. [14] Analysis of Total Phenols and Other Oxidation Substrates and Antioxidants by Means of Folin-Ciocalteu Reagent. In Oxidants and Antioxidants Part A; Elsevier: Amsterdam, The Netherlands, 1999; pp. 152–178. ISBN 9780121822002. [Google Scholar]
- Zhishen, J.; Mengcheng, T.; Jianming, W. The Determination of Flavonoid Contents in Mulberry and Their Scavenging Effects on Superoxide Radicals. Food Chem. 1999, 64, 555–559. [Google Scholar] [CrossRef]
- Kumar, S.; Jyotirmoyee, K.; Sarangi, M. Thin Layer Chromatography: A Tool of Biotechnology for Isolation of Bioactive Compounds from Medicinal Plants. Int. J. Pharm. Sci. Rev. Res. 2013, 18, 126–132. [Google Scholar]
- Kagan, I.A.; Flythe, M.D. Thin-Layer Chromatographic (TLC) Separations and Bioassays of Plant Extracts to Identify Antimicrobial Compounds. J. Vis. Exp. 2014, e51411. [Google Scholar] [CrossRef]
- Davies, N.W. Gas Chromatographic Retention Indices of Monoterpenes and Sesquiterpenes on Methyl Silicon and Carbowax 20-M Phases. J. Chromatogr. A 1990, 503, 1–24. [Google Scholar] [CrossRef]
- Kumar, G.; Gupta, R.; Sharan, S.; Roy, P.; Pandey, D.M. Anticancer Activity of Plant Leaves Extract Collected from a Tribal Region of India. 3 Biotech 2019, 9, 399. [Google Scholar] [CrossRef]
- Correa, P.; Haenszel, W. The Epidemiology of Large-Bowel Cancer. Adv. Cancer Res. 1978, 26, 1–141. [Google Scholar] [CrossRef]
- Prakash, O.; Kumar, A.; Kumar, P.; Ajeet, A. Anticancer Potential of Plants and Natural Products: A Review. Am. J. Pharmacol. Sci. 2013, 1, 104–115. [Google Scholar] [CrossRef]
- Prichard, R. Anthelmintic Resistance. Vet. Parasitol. 1994, 54, 259–268. [Google Scholar] [CrossRef]
- Chegu, K.; Mounika, K.; Rajeswari, M.; Vanibala, N.; Sujatha, P.; Sridurga, P. In Vitro Study of the Anticoagulant Activity of Some Plant Extracts. World J. Pharm. Pharm. Sci. 2018, 7, 904–913. [Google Scholar]
- Jorgensen, J.H.; Turnidge, J.D. Susceptibility Test Methods: Dilution and Disk Diffusion Methods. In Manual of Clinical Microbiology; ASM Press: Washington, DC, USA, 2015; pp. 1253–1273. [Google Scholar]
- Arora, D.S.; Sood, H. In Vitro Antimicrobial Potential of Extracts and Phytoconstituents from Gymnema sylvestre R.Br. Leaves and Their Biosafety Evaluation. AMB Express 2017, 7, 115. [Google Scholar] [CrossRef] [PubMed]
- Onsare, J.G.; Arora, D.S. Antibiofilm Potential of Flavonoids Extracted from Moringa oleifera Seed Coat against Staphylococcus aureus, Pseudomonas aeruginosa and Candida albicans. J. Appl. Microbiol. 2015, 118, 313–325. [Google Scholar] [CrossRef] [PubMed]
- Miller, G.L. Use of dinitrosalicylic acid reagent for determination of reducing sugar. Anal. Chem. 1959, 31, 426–428. [Google Scholar] [CrossRef]
- Rice-Evans, C.A.; Miller, N.J.; Paganga, G. Structure-Antioxidant Activity Relationships of Flavonoids and Phenolic Acids. Free Radic. Biol. Med. 1996, 20, 933–956. [Google Scholar] [CrossRef]
- Freed, D.M.; Bessman, N.J.; Kiyatkin, A.; Salazar-Cavazos, E.; Byrne, P.O.; Moore, J.O.; Valley, C.C.; Ferguson, K.M.; Leahy, D.J.; Lidke, D.S.; et al. EGFR Ligands Differentially Stabilize Receptor Dimers to Specify Signaling Kinetics. Cell 2017, 171, 683–695.e18. [Google Scholar] [CrossRef]
- Shilpakar, A.; Gaire, B.P.; Bahadur, S.C.; Lamichhane, R.; Neupane, S. Phytochemical Screening and Analysis of Antibacterial and Antioxidant Activity of Ficus auriculata, Lour. Stem Bark; Pokhara University: Lekhnath, Nepal, 2009. [Google Scholar]
- De, S.; Dey, Y.N.; Ghosh, A.K. Phytochemical Investigation and Chromatographic Evaluation of the Different Extracts of Tuber of Amorphaphallus paeoniifolius (Araceae). Int. J. Pharm. Biol. Res 2010, 1, 150–157. [Google Scholar]
- Harborne, A.J. Phytochemical Methods a Guide to Modern Techniques of Plant Analysis; Springer Science + Business Media: Berlin/Heidelberg, Germany, 1998. [Google Scholar]
- Parekh, J.; Chanda, S. In Vitro Antimicrobial Activity and Phytochemical Analysis of Some Indian Medicinal Plants. Turk. J. Biol. 2007, 31, 53–58. [Google Scholar]
- Edeoga, H.O.; Okwu, D.E.; Mbaebie, B.O. Phytochemical Constituents of Some Nigerian Medicinal Plants. Afr. J. Biotechnol. 2005, 4, 685–688. [Google Scholar] [CrossRef]
- Dhandapani, R.; Sabna, B. Phytochemical Constituents of Some Indian Medicinal Plants. Anc. Sci. Life 2008, 27, 1–8. [Google Scholar]
- Mace, M.E.; Bell, A.A.; Beckman, C.H. Histochemistry and Identification of Disease-Induced Terpenoid Aldehydes in Verticillium-Wilt-Resistant and-Susceptible Cottons. Can. J. Bot. 1976, 54, 2095–2099. [Google Scholar] [CrossRef]
- Kumar, P.P.; Kumaravel, S.; Lalitha, C. Screening of Antioxidant Activity, Total Phenolics and GC-MS Study of Vitex negundo. Afr. J. Biochem. Res. 2010, 4, 191–195. [Google Scholar]
- Onwukaeme, D.N.; Ikuegbvweha, T.B.; Asonye, C.C. Evaluation of Phytochemical Constituents, Antibacterial Activities and Effect of Exudate of Pycanthus angolensis Weld Warb (Myristicaceae) on Corneal Ulcers in Rabbits. Trop. J. Pharm. Res. 2007, 6, 725–730. [Google Scholar] [CrossRef]
- Dahiru, D.; Onubiyi, J.A.; Umaru, H.A. Phytochemical Screening and Antiulcerogenic Effect of Moringa oleifera Aqueous Leaf Extract. Afr. J. Trad. Complement. Altern. Med. 2006, 3, 70–75. [Google Scholar] [CrossRef]
- Ben Khadher, T.; Sassi-Aydi, S.; Aydi, S.; Mars, M.; Bouajila, J. Phytochemical Profiling and Biological Potential of Prunus dulcis Shell Extracts. Plants 2023, 12, 2733. [Google Scholar] [CrossRef]
- Youssef, A.M.M.; Maaty, D.A.M.; Al-Saraireh, Y.M. Phytochemical Analysis and Profiling of Antitumor Compounds of Leaves and Stems of Calystegia silvatica (Kit.) Griseb. Molecules 2023, 28, 630. [Google Scholar] [CrossRef] [PubMed]
- Puranik, S.I.; Ghagane, S.C.; Nerli, R.B.; Jalalpure, S.S.; Hiremath, M.B. Evaluation of In Vitro Antioxidant and Anticancer Activity of Simarouba glauca Leaf Extracts on T-24 Bladder Cancer Cell Line. Pharmacogn. J. 2017, 9, 906–912. [Google Scholar] [CrossRef]
- Niezen, J.H.; Waghorn, G.C.; Charleston, W.A. Growth and Gastrointestinal Nematode Parasitism in Lambs Grazing Either Lucerne (Medicago sativa) or (Hedysarum coronarium), Which Contains Condensed Tannins. J. Agric. Sci. 1995, 125, 281–289. [Google Scholar] [CrossRef]
- Shrestha, B.; Basnett, H.; Babu, V.D.; Patel, S.S. Anthelmintic and Antimicrobial Activity of the Chloroform Extract of Pergularia Daemia Forsk Leaves. Adv. Pharmacol. Toxicol. 2009, 10, 13–16. [Google Scholar]
- Athanasiadou, S.; Kyriazakis, I.; Jackson, F.; Coop, R.L. Direct Anthelmintic Effects of Condensed Tannins Towards Different Gastrointestinal Nematodes of Sheep: In Vitro and In Vivo Studies. Vet. Parasitol. 2001, 99, 205–219. [Google Scholar] [CrossRef] [PubMed]
- Thompson, D.P.; Geary, T.G. The Structure and Function of Helminth Surfaces. In Biochemistry and Molecular Biology of Parasites, 1st ed.; Marr, J.J., Ed.; Academic Press: Cambridge, MA, USA, 1995; pp. 203–232. [Google Scholar]
- Chandrashekhar, C.H.; Latha, K.P.; Vagdevi, H.M.; Vaidya, V.P. Anthelmintic Activity of the Crude Extracts of Ficus racemosa. Int. J. Green Pharm. 2008, 2, 100–103. [Google Scholar]
- Atanasov, A.G.; Zotchev, S.B.; Dirsch, V.M.; International Natural Product Sciences Taskforce; Supuran, C.T. Natural Products in Drug Discovery: Advances and Opportunities. Nat. Rev. Drug Discov. 2021, 20, 200–216. [Google Scholar] [CrossRef] [PubMed]
- Tungmunnithum, D.; Thongboonyou, A.; Pholboon, A.; Yangsabai, A. Flavonoids and Other Phenolic Compounds from Medicinal Plants for Pharmaceutical and Medical Aspects: An Overview. Medicines 2018, 5, 93. [Google Scholar] [CrossRef] [PubMed]
- AlSheikh, H.M.A.; Sultan, I.; Kumar, V.; Rather, I.A.; Al-Sheikh, H.; Tasleem Jan, A.; Haq, Q.M.R. Plant-Based Phytochemicals as Possible Alternative to Antibiotics in Combating Bacterial Drug Resistance. Antibiotics 2020, 9, 480. [Google Scholar] [CrossRef]
- Dirir, A.M.; Daou, M.; Yousef, A.F.; Yousef, L.F. A Review of Alpha-Glucosidase Inhibitors from Plants as Potential Candidates for the Treatment of Type-2 Diabetes. Phytochem. Rev. 2022, 21, 1049–1079. [Google Scholar] [CrossRef]
- Ramana, K.V.; Reddy, A.B.M.; Majeti, N.V.R.K.; Singhal, S.S. Therapeutic Potential of Natural Antioxidants. Oxid. Med. Cell. Longev. 2018, 2018, 9471051. [Google Scholar] [CrossRef]
- Mannan, A.; Rahman, M.M.; Habib, M.R.; Hasan, M.A.; Al Amin, M.; Saha, A. Comparative Assessment on in Vitro Antioxidant Activities of Ethanol Extracts of Averrhoa bilimbi, Gymnema sylvestre and Capsicum frutescens. Pharmacogn. Res. 2014, 6, 36. [Google Scholar] [CrossRef]
- Kang, M.-H.; Lee, M.S.; Choi, M.-K.; Min, K.-S.; Shibamoto, T. Hypoglycemic Activity of Gymnema sylvestre Extracts on Oxidative Stress and Antioxidant Status in Diabetic Rats. J. Agric. Food Chem. 2012, 60, 2517–2524. [Google Scholar] [CrossRef]
- Shaikh, I.A.; Alshabi, A.M.; Alkahtani, S.A.; Orabi, M.A.A.; Abdel-Wahab, B.A.; Walbi, I.A.; Habeeb, M.S.; Khateeb, M.M.; Shettar, A.K.; Hoskeri, J.H. Apoptotic Cell Death via Activation of DNA Degradation, Caspase-3 Activity, and Suppression of Bcl-2 Activity: An Evidence-Based Citrullus Colocynthis Cytotoxicity Mechanism Toward MCF-7 and A549 Cancer Cell Lines. Separations 2022, 9, 411. [Google Scholar] [CrossRef]
- Ashmawy, F.O.; Gomha, S.M.; Abdallah, M.A.; Zaki, M.E.A.; Al-Hussain, S.A.; El-Desouky, M.A. Synthesis, In Vitro Evaluation and Molecular Docking Studies of Novel Thiophenyl Thiazolyl-Pyridine Hybrids as Potential Anticancer Agents. Molecules 2023, 28, 4270. [Google Scholar] [CrossRef] [PubMed]
- Choudhary, N.; Khatik, G.L.; Choudhary, S.; Singh, G.; Suttee, A. In Vitro Anthelmintic Activity of Chenopodium album and in-Silico Prediction of Mechanistic Role on Eisenia foetida. Heliyon 2021, 7, e05917. [Google Scholar] [CrossRef] [PubMed]
- Visioli, F.; Borsani, L.; Galli, C. Diet and Prevention of Coronary Heart Disease: The Potential Role of Phytochemicals. Cardiovasc. Res. 2000, 47, 419–425. [Google Scholar] [CrossRef] [PubMed]
- Okazaki, K.; Nakayama, S.; Kawazoe, K.; Takaishi, Y. Antiaggregant Effects on Human Platelets of Culinary Herbs. Phytother. Res. 1998, 12, 603–605. [Google Scholar] [CrossRef]
- Parast, Y.; Saei, R. Effects of Aqueous Tarragon, Artemisia Dracunculus, Extract on Lipid and Coagulatory Parameters in Rats. Biol. Med. Lett. 1999, 59, 137–141. [Google Scholar]
Disclaimer/Publisher’s Note: The statements, opinions and data contained in all publications are solely those of the individual author(s) and contributor(s) and not of MDPI and/or the editor(s). MDPI and/or the editor(s) disclaim responsibility for any injury to people or property resulting from any ideas, methods, instructions or products referred to in the content. |
© 2024 by the authors. Licensee MDPI, Basel, Switzerland. This article is an open access article distributed under the terms and conditions of the Creative Commons Attribution (CC BY) license (https://creativecommons.org/licenses/by/4.0/).